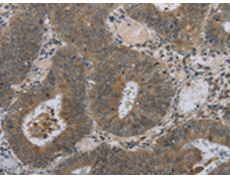
一抗

抗 原: HSD3B1
技術規(guī)格
|
Background: |
HSD3B1 is a human gene that encodes for a 3beta-hydroxysteroid dehydrogenase/delta(5)-delta(4)isomerase type I or hydroxy-delta-5-steroid dehydrogenase, 3 beta- and steroid delta-isomerase 1. While it can carry out the same function as HSD3B2, it localizes primarily to different tissues, such as the placenta and nonsteroidogenic tissues. Its requirement for the production of progesterone by the placenta, which has a vital role in pregnancy, may be one reason why no disease based on mutations in this gene has been identified to date. |
|
Applications: |
ELISA, IHC |
|
Name of antibody: |
HSD3B1 |
|
Immunogen: |
Fusion protein of human HSD3B1 |
|
Full name: |
hydroxy-delta-5-steroid dehydrogenase, 3 beta- and steroid delta-isomerase 1 |
|
Synonyms: |
I; HSD3B; HSDB3; HSDB3A; SDR11E1; 3BETAHSD |
|
SwissProt: |
P14060 |
|
ELISA Recommended dilution: |
2000-5000 |
|
IHC positive control: |
Human colon cancer |
|
IHC Recommend dilution: |
50-200 |


 購物車
購物車 幫助
幫助
 021-54845833/15800441009
021-54845833/15800441009